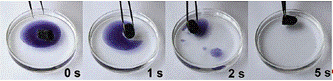

Материал: Аэрогель
Аэрогель
МИНИСТЕРСТВО ОБРАЗОВАНИЯ И НАУКИ РОССИЙСКОЙ ФЕДЕРАЦИИ
Федеральное государственное автономное образовательное учреждение высшего профессионального образования
«САНКТ-ПЕТЕРБУРГСКИЙ ГОСУДАРСТВЕННЫЙ УНИВЕРСИТЕТ АЭРОКОСМИЧЕСКОГО ПРИБОРОСТРОЕНИЯ»
КАФЕДРА
ТЕХНИЧЕСКОЙ ФИЗИКИ, ЭЛЕКТРОМЕХАНИКИ И РОБОТОТЕХНИКИ
РЕФЕРАТ
Аэрогель
по
дисциплине: Микро- и нанотехнологии
ВЫПОЛНИЛ
СТУДЕНТ ГР. 3321
А. И. Казаков
Санкт-Петербург 2015
Содержание
Введение
. Что такое аэрогель?
. Получение
3. Свойства
4. Применение
Заключение
Список
использованных источников
Введение
Одним из необычных материалов, созданных человеком, и, одновременно, самым легким материалом в мире считается аэрогель. Уникальные свойства такого материала в последние дни привлекают все большее внимание не только физиков, изучающих атомные ядра и элементарные частицы. Значительный интерес в исследовательских центрах (США, Германии и др.) проявляют к использованию уникальных свойств аэрогелей в прикладных целях, таких как создание эффективных теплоизоляторов, носителей катализаторов, звукоизоляторов, поглотителей и фильтров для газов и жидкостей и т. п.
1. Что такое аэрогель?
Аэрогель (иначе его еще называют замороженным или твердым дымом) можно
сравнить с затвердевшей мыльной пеной. Аэрогели (от лат. aer - воздух и gelatus
- замороженный) - класс материалов, представляющих собой гель, в котором жидкая
фаза полностью замещена газообразной. Это материалы с большой площадью
поверхности, малой плотностью, состоящие из блоков частиц, соединенных вместе и
образующих высокопористую структуру, как видно на рисунке 1.1.

Рисунок 1.1 - Аэрогель в руках ученого
Вещества группы аэрогелей, которые порой называют "твердый газ", "голубой дым" или "замороженный дым", как видно на рисунке 1.2, известны достаточно давно. История открытия аэрогелей весьма интересна. В 1931 году американский химик Стивен Кистлер из Тихоокеанского колледжа Калифорния, поспорил с коллегой Чарльзом Лернедом, что сможет заменить всю жидкость в желе на газ без малейшей усадки объема вещества. Так на свет явился первый образец "замороженного дыма" - полупрозрачного аэрогеля со сверхнизкой плотностью, на ощупь напоминающего пенополистирол.

Рисунок 1.2 - Аэрогель - он же замороженный дым
Вероятно, самая близкая аналогия аэрогелям, которую образно несложно представить каждому - это пенопласт. Но в случае аэрогелей "перегородки" состоят из наночастиц размером 2-5 нм, а полые поры имеют размер менее 100 нм. Таким образом, хотя аэрогель классифицируется как твердое вещество, до 99% его субстанции - это ни что иное как газ. Однако, по словам ученых, в силу наноразмеров внутренней структуры подобных веществ - пор и "перегородок", одного кубического сантиметра аэрогеля было бы достаточно, чтобы, будучи "развернутыми", эти самые "перегородки" покрыли площадь футбольного поля.
Поэтому структура является настолько мелкоячеистой, что глаз отказывается различать эти ячейки даже под микроскопом (диаметр пор - 20 нанометров) и такой легкой, что ее плотность лишь в два с половиной раза больше плотности воздуха. Кстати, материал, созданный в JPL и использованный в этой ловушке, попал в книгу Гиннеса, как твердое тело с самой низкой плотностью (3 миллиграмма на кубический сантиметр). Такие материалы кроме рекордно низкой плотности и демонстрируют ряд уникальных свойств: твердость, прозрачность, жаропрочность и т.д.
И при этом пена довольно прочна. Так что на приличный кусок аэрогеля можно спокойно положить кирпич. Прочность аэрогеля на разрыв совсем невелика по сравнению с конструкционными материалами, однако, многократно выше, чем, скажем, у мыльной пены, с которой его невольно хочется сравнить. При сильной нагрузке аэрогель трескается, но в целом это весьма прочный материал - образец аэрогеля может выдержать нагрузку в 2000 раз больше собственного веса. За счет релеевского рассеяния света на древовидных структурах они выглядят голубоватыми в отраженном свете и светло-желтыми в проходящем.
Распространены аэрогели на основе аморфного диоксида кремния (SiO2),
глиноземов (Al2O3), а также оксидов хрома и олова. В
начале 1990-х получены первые образцы аэрогеля на основе углерода. Наиболее
распространены кварцевые (Si)
аэрогели, им также принадлежит текущий рекорд по самой малой плотности у
твердых тел - 1,9 кг/м³, в 500 раз меньше плотности воды. До начала 2000-х
годов главным недостатком всех аэрогелей была хрупкость. Однако создание новых
материалов из углерода - графена и углеродных нанотрубок - позволило получать
пластичные и устойчивые к ударному воздействию аэрогели. Благодаря этому, а
также чрезвычайно низкой теплопроводности (0,003 Вт/(м·К)), они применяются в
строительстве в качестве теплоизолирующих и теплоудерживающих материалов,
2,5-сантиметровый лист из силиконового аэрогеля защищает руку человека от огня
паяльной лампы, что подобное с цветком видно на рисунке 1.4. Температура
плавления кварцевого аэрогеля составляет 1200°C [1].
2.
Получение
Как не показалось бы странным, история аэрогеля насчитывает более 70 лет. Первый аэрогель получил американский ученый Стивен Кистлер где-то в конце 1920-х или 1930-м году. В это время он работал в Тихоокеанском колледже в Стоктоне (Калифорния). Официальной датой рождения аэрогеля принято считать 1931 год, что точно не установлено, когда Кистлер опубликовал статью о свой работе в журнале Nature.
Рассказать о производстве аэрогеля легко, но на практике процесс довольно затруднителен. При удалении жидкости из геля его твердая составляющая, обычно, разрушается. Она теряет прочную структуру, меняет форму, сложные молекулярные сети рассыпаются.
Заставить микроскопическую структуру "пену" сохраниться при удалении заполняющей ее жидкости, очень трудно. Зато при выполнении поставленной задачи получится материал с удивительными свойствами: плотность современных аэрогелей от 0,35 до 0,003 граммов на кубический сантиметр (плотность воздуха - 0,0012 граммов на кубический сантиметр).
Для реализации задуманного сначала используется ряд химических реакций для образования влажного геля. Затем полученный продукт полимеризуется, порой по 2-3 суток, превращаясь в своеобразное желе. Затем из него с помощью спирта удаляется вода (ее полное удаление - обязательно). Потом в автоклаве при высоком давлении и температуре проводится так называемое "суперкритическое" высыхание с участием жидкого углекислого газа [1].
Принципиальное значение имеет последний процесс образования аэрогеля, связанный с его сушкой, т. е. с удалением молекул жидкости, находящихся в его порах. Поскольку аэрогель имеет много микроскопических пор, нахождение в них молекул жидкости создает там высокие давления. Например, оценки дают, что в порах аэрогеля двуокиси кремния с диаметром 2 нм молекулы воды создают давление порядка 20 кбар. Поэтому высушивание аэрогелей в атмосферном воздухе или в вакууме создает большие внутренние напряжения в его каркасе, что приводит к его сжатию, а возможно и разрушению. Высушенный таким способом аэрогель, который носит название ксерогеля, сохраняет пористость структуры, однако его удельный вес существенно выше, а удельный объем внутренних пор значительно ниже, чем у аэрогеля.

Рисунок 2.1 - Структуры, образующиеся при сушке геля
Проблема сушки аэрогеля была решена Кистлером в начале тридцатых годов, что позволило ему получить образцы аэрогеля двуокиси кремния и исследовать его свойства. С работ Кистлера и начинается история аэрогеля. Для сушки аэрогеля Кистлер помещал его в автоклав, где достигались сверхкритические температура и давление для находящейся в порах аэрогеля жидкости. Испарение этой жидкости при сверхкритических параметрах и замена ее газом позволяет в последующем сохранить внутреннюю структуру аэрогеля. В последующем именно этим методом и осуществляли сушку аэрогеля.
Для получения представления о реальных способах получения аэрогеля приводится здесь используемые подходы в случае аэрогеля двуокиси кремния. В классическом способе, использованном Кистлером, исходным веществом была соль Na2SiO3, которая помещалась в водный раствор соляной кислоты, что приводило к химической реакции. Соль выпадала в осадок и удалялась из раствора. Оставшийся раствор промывался и фильтровался, в полученном растворе вода заменялась метиловым или этиловым спиртом, который обладает более низкими значениями критического давления и температуры, чем вода. Далее, в автоклаве при сверхкритических условиях производилась сушка аэрогеля. Обычно к перечисленным фазам образования аэрогеля добавляется еще одна - отжиг при атмосферном давлении. Такая операция существенно повышает прозрачность аэрогеля [2]. Первым аэрогелем, полученным в лаборатории Кистлера, стал более известный силикагель (silica gel, гель кремниевой кислоты), который нынче повсеместно используется в качестве вещества для эффективного поглощения влаги. Несколько позднее Кистлер открыл аэрогели на основе окиси алюминия, алюмохромовые и окиси олова.
3.
Свойства
Благодаря своей структуре аэрогели обладают набором уникальных свойств.
Хотя их прочность приближается к прочности твердых тел, что видно на рисунке
3.1, по плотности они близки к газам. Так, лучшие образцы кварцевого аэрогеля
имеют плотность около 2 мг/см3 (плотность входящего в их состав воздуха - 1,2
мг/см3), что в тысячу раз меньше, чем у непористых твердых материалов.

Рисунок 3.1 - Кирпич массой 2,5 кг стоит на куске аэрогеля массой 2,38 г
Аэрогели обладают и крайне малой теплопроводностью, это видно на рисунке
3.2, поскольку теплу нужно пройти сложный путь по разветвленной сети из очень
тонких цепочек наночастиц. При этом перенос тепла по воздушной фазе также
затруднен из-за того, что эти же цепочки делают невозможной конвекцию, без
которой теплопроводность воздуха очень низка.

Рисунок 3.2 - Цветок защищен от пламени пластиной аэрогеля
Еще одно свойство аэрогеля - его необычайная пористость - позволило
доставить на Землю образцы межпланетной пыли с помощью космического аппарата
Stardust. Его устройство сбора представляло собой блок аэрогеля, попадая в
который, частицы пыли останавливались с ускорением несколько миллиардов g, не
разрушаясь, это видно на рисунке 3.3.

Рисунок 3.3 - Аэрогель после тестового обстрела частицами на Земле в процессе подготовки миссии Stardust
Главным недостатком аэрогеля до недавнего времени была его хрупкость: он растрескивался при повторных нагрузках. Все полученные на тот момент аэрогели - из кварца, некоторых оксидов металлов и углерода - обладали этим недостатком. Но с появлением новых углеродных материалов - графена и углеродных нанотрубок - проблема получения эластичных и устойчивых к разрушению аэрогелей была решена.
Графен - это лист толщиной в один атом, в котором атомы углерода образуют гексагональную решетку (каждая клетка решетки - шестиугольник), а углеродная нанотрубка - это такой же лист, свернутый в цилиндр толщиной от одного до десятков нанометров. Эти формы углерода обладают большой механической прочностью, эластичностью, очень высокой площадью внутренней поверхности, а так же высокой тепло- и электропроводностью.
Однако материалы, приготовленные отдельно из графена или отдельно из углеродных нанотрубок, тоже имеют свои недостатки. Так, аэрогель из графена плотностью 5,1 мг/см3 не разрушался под нагрузкой, превосходящей его собственный вес в 50 000 раз, и восстанавливал форму после сжатия на 80% от исходного размера. Однако из-за того, что графеновые листы обладают недостаточной жесткостью при изгибе, уменьшение их плотности ухудшает упругие свойства аэрогеля из графена.
Как продемонстрировала группа китайских ученых, эти недостатки полностью компенсируются, если использовать при приготовлении аэрогеля одновременно графен и нанотрубки. В получившейся структуре графеновые листы служили каркасом, а нанотрубки - ребрами жесткости на этих листах. Как показали исследования под электронным микроскопом, графеновые листы перекрываются друг с другом и образуют трехмерный каркас с порами размером от десятков нанометров до десятков микрометров, а углеродные нанотрубки образуют перепутанную сеть и плотно прилегают к графеновым листам.
Плотность образца составила 1 мг/см3 без учета воздуха. А
согласно расчетам в представленной авторами структурной модели, минимальная
плотность, при которой аэрогель из использованных исходных веществ еще сохранит
целостность структуры, составляет 0,13 мг/см3, что почти в 10 раз меньше
плотности воздуха, как видно на рисунке 3.4! Авторы смогли приготовить
композитный аэрогель с плотностью 0,45 мг/см3 и аэрогель только из графена
плотностью 0,16 мг/см3, что меньше предыдущего рекорда, принадлежащего аэрогелю
из ZnO, осажденному на субстрат из газовой фазы. Уменьшения плотности можно
достичь, используя более широкие листы графена, но при этом снижается жесткость
и прочность полученного материала.

Рисунок 3.4 - Кусок аэрогеля, изготовленный из графена и нанотрубок
При испытаниях образцы такого композитного аэрогеля сохраняли форму и микроструктуру после 1000 повторных сжатий на 50% от исходного размера. В диапазоне от -190°С до 300°С упругие свойства полученных аэрогелей почти не зависят от температуры.
Испытания на разрыв были проведены для образца с плотностью 1 мг/см3, и образец выдержал растяжение на 16,5%, что совершенно немыслимо для оксидных аэрогелей, которые при растяжении трескаются сразу. Кроме того, жесткость при растяжении выше, чем при сжатии, то есть образец сминается легко, а растягивается с трудом.
Этот набор свойств авторы объяснили синергетическим взаимодействием графена и нанотрубок, при котором свойства компонентов взаимно дополняют друг друга. Оптимальными свойствами обладает аэрогель, состоящий поровну из графена и нанотрубок, а с увеличением содержания нанотрубок они начинают образовывать «колтуны», как в аэрогеле только из нанотрубок, что приводит к потере эластичности.
Рисунок 3.5 - Абсорбция аэрогеля
4.
Применение
В космических экспериментах на борту шаттлов и в аппарате Stardust,
слетавшем недавно к комете, в марсианских роверах Mars Pathfinder, Spirit и
Opportunity применялся тот самый аэрогель, как видно на рисунке 4.1. На 99,8%
состоящий из воздуха, в открытом космосе, соответственно, основной объем
составляет вакуум, что не мешает ему по-прежнему сохранять свою прочность.

Рисунок 4.1 - Соты из алюминия, заполненные аэрогелем
Новый всплеск интереса к ним пришелся на последние годы. В различных лабораториях NASA, других исследовательских организациях США (Ливермор, Беркли) начали создавать многочисленные новые образцы аэрогелей (опять-таки, прежде всего, из кремния), которые еще ярче демонстрировали достоинства этого типа материала XXI века. О "пене", вспомнили, когда задумали эксперимент Stardust. В январе 2004 года этот космический аппарат NASA прошел через хвост кометы Wild 2. Изготовленная из аэрогеля огромная ловушка оказалась тем искомым способом, позволившим поймать и остановить частицы кометной пыли, пролетающие мимо аппарата со скоростью 6 километров в секунду. С применением иного вещества они или испарились бы, или разрушились настолько, что их нельзя было бы изучить.